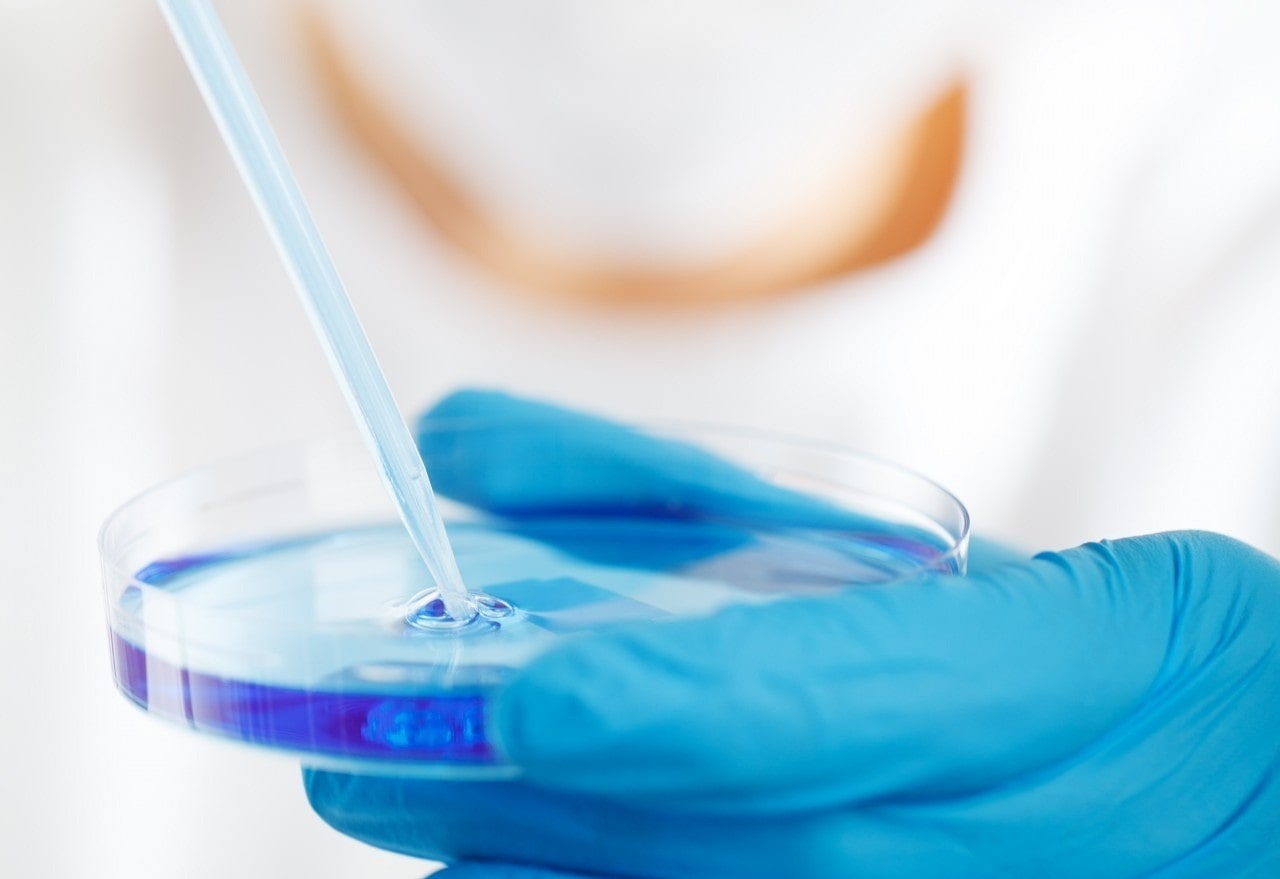
Caso di meningite a Perugia: allerta per i partecipanti a una festa di Halloween in discoteca - immagine di copertina

Scatta l’allerta sanitaria a Perugia, dove è stato segnalato un caso di meningite meningococcica. Il paziente avrebbe partecipato a una festa di Halloween nella discoteca Urban Club il 31 ottobre, dopo aver manifestato i primi sintomi il 5 novembre. Il periodo di contagiosità da meningite va collocato nei 7 giorni precedenti (dal 29 ottobre al 5 novembre) e include quindi anche la serata della festa, evento che ha attirato molti giovani a Perugia e in cui il rischio di contatti stretti era molto elevato.
Vista la difficoltà nel rintracciare tutti i partecipanti al party, la Usl Umbria 1 ha diffuso una nota invitando chi era presente a rivolgersi tempestivamente al proprio medico per la profilassi antibiotica. Tale trattamento preventivo è raccomandato per coloro che potrebbero essere entrati in contatto stretto con il paziente, al fine di limitare la diffusione della malattia. Già sottoposti a profilassi, i familiari e gli amici più prossimi del paziente.
Che cos’è la meningite meningococcica e come si trasmette
La meningite meningococcica è un’infiammazione delle meningi, le membrane che avvolgono il cervello e il midollo spinale, causata dal batterio Neisseria meningitidis (meningococco). Questa forma di meningite è tra le più gravi e si diffonde principalmente tramite contatti aerei stretti, come tosse, starnuti o baci, motivo per cui luoghi affollati e chiusi facilitano il contagio.
Il batterio non sopravvive a lungo fuori dal corpo umano, quindi la sanificazione degli ambienti non è necessaria. Il periodo di incubazione della meningite meningococcica è di solito compreso tra i 2 e i 10 giorni, ma il rischio di trasmissione è limitato ai 7 giorni precedenti l’insorgenza dei sintomi.
All’inizio, i sintomi della meningite possono essere confusi con altre malattie. Febbre alta, mal di testa persistente e rigidità del collo sono i classici segnali, a cui si aggiungono spesso nausea, vomito, sensibilità alla luce e, nei casi più gravi, convulsioni e stato confusionale. Poiché la malattia può progredire rapidamente, è essenziale riconoscere i sintomi e iniziare tempestivamente il trattamento antibiotico.



